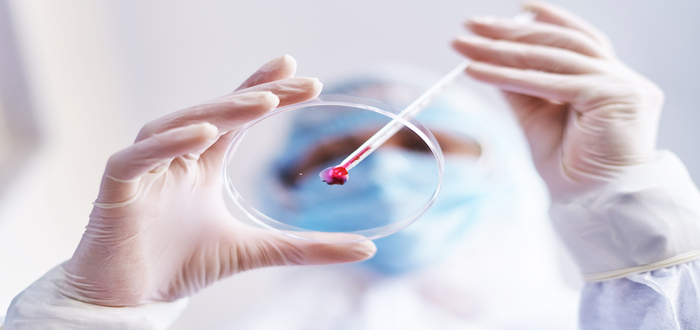

Um dos maiores centros médicos de São Paulo, o Hospital Santa Marcelina é referência em atendimento
O Hospital Santa Marcelina atua há 59 anos como uma das principais referências hospitalares da Zona Leste de São Paulo. Com mais de 700 leitos, que atendem tanto convênios privados quanto pacientes do Sistema Único de Saúde, 111 UTI’s e mais de mil médicos, a estrutura do hospital é comparável com os melhores centros médicos do país.
O Santa Marcelina também se destaca como um importante centro de pesquisa e ensino, com 42 programas de residência médica, multiprofissional e especialização.
Tendo como objetivo oferecer assistência, ensino e pesquisa em Saúde com excelência e valores humanitários, o Hospital Santa Marcelina busca atender o maior número de pessoas possível.

Serviços e tratamentos do Hospital Santa Marcelina
O Hospital Santa Marcelina conta com completa infraestrutura, protocolos de qualidade, equipamentos de última geração e uma equipe médica treinada e capacitada para oferecer tratamentos de ponta para os pacientes. São mais de 60 especialidades e diversos serviços disponíveis, confira.
Banco de sangue
O Hospital Santa Marcelina realiza por mês entre 4.000 a 6.000 transfusões de sangue e outros hemocomponentes (hemácias, plasma, plaquetas, crioprecipitado, etc) em pacientes internados, ambulatoriais. Além disso, o centro médico também auxilia no fornecimento de bolsas de sangue e hemocomponentes para diversos hospitais.
Diagnóstico por imagem
O hospital também conta com um setor de Diagnóstico por Imagem completo, composto pelas áreas de radiologia, ultrassonografia, tomografia computadorizada, imagens de mama e ressonância magnética. Os procedimentos realizados são:
- Procedimentos realizados pelo setor:
- Ressonância magnética;
- Tomografia computadorizada;
- Mamografia;
- Ultrassonografia;
- Densitometria;
- Radiologia Geral;
- Urografia Excretora.
Hemodinâmica
Sendo o único hospital na região leste com atendimento em alta complexidade para os diversos tipos de patologias relacionadas à radiologia intervencionista, o Hospital Santa Marcelina conta com o serviço de hemodinâmica amplamente qualificado em recursos humanos e tecnológicos. Confira abaixo:
- Acessos vasculares: quimioterapia, hemodiálise e transplante de medula óssea;
- Angiografias (inclusive medular);
- Angioplastia;
- Angioplastia de carótidas, artéria vertebral, vasos intracranianos;
- Cateterismo cardíaco;
- Embolização de aneurismas e tumores cerebrais;
- Embolizações periféricas;
- Intervenção biliar;
- Má formação arteriovenosa central;
- Tratamento endovascular de aneurisma;
- Valvoplastia.
Centro cirúrgico do Hospital Santa Marcelina

O Centro Cirúrgico do hospital segue os mais rigorosos padrões de qualidade dos centros médicos de ponta de São Paulo. Com inúmeras especialidades cirúrgicas atendidas, o setor inclui cirurgias de média e alta complexidades, como transplantes renais (intervivos), medula óssea e tratamentos avançados de câncer
Internação
A preocupação com o conforto dos pacientes se estende ao proporcionar a visita ampliada, que ocorre das 11h às 20h. Desta forma, o paciente tem a possibilidade de contar com a presença constante do familiar ou acompanhante no leito, auxiliando na agilidade do tratamento, o que contribui rapidamente para a alta.
Maternidade
A unidade realiza cerca de 2,4 mil partos por ano. O serviço prestado a convênios contempla desde o atendimento pré e pós-natal em ambulatório próprio, exames laboratoriais e de imagem (USG obstétrico morfológico e com doppler), Pronto-Socorro e Maternidade 24 horas, tanto para gestação de alto risco quanto para de baixo risco.
Pediatria
Com três unidades de internação pediátrica, o Hospital Santa Marcelina de Itaquera prioriza o atendimento humanizado e atividades lúdicas para estimular a interação dos pacientes, minimizando possíveis traumas no período de internação.
Unidades de terapia intensiva
As Unidades de Terapia Intensiva do hospital oferecem suporte avançado de vida aos pacientes, totalizando mais de 100 leitos, divididos em UTI Geral, UTI Neonatal e UTI Pediátrica, tendo atendimento realizado com base em uma infraestrutura moderna e com equipamentos de alta tecnologia para monitoramento completo e vigilância 24 horas.
Oncologia
A oncologia do Hospital Santa Marcelina prioriza o bem-estar do paciente e a medicina humanizada, reunindo os melhores profissionais da área da saúde, a fim de colaborar com o desenvolvimento de pesquisas e estudos, além de aplicar as mais modernas técnicas de prevenção e diagnóstico.
Pronto-socorro do Hospital Santa Marcelina
O Pronto-Socorro do Hospital Santa Marcelina é uma unidade referenciada na rede de urgência e emergência, que prioriza os atendimentos de alta complexidade e casos em que realmente há risco de morte. O atendimento segue um fluxo que visa priorizar casos de urgência e emergência e, desta forma, ampliar a sobrevida de pacientes que precisam de atendimento imediato.
Unidade de Acidente vascular Cerebral
A Unidade de Acidente Vascular Cerebral do Hospital Santa Marcelina de Itaquera é um Serviço de Neurologia e tem como objetivo principal o atendimento imediato e cuidado intensivo dos pacientes com acidente vascular cerebral, visando reduzir a mortalidade e morbidade desses pacientes e, em consequência, reduzir o tempo de internação.
Parkinson
O Hospital Santa Marcelina é um dos três hospitais do Estado de São Paulo que realiza cirurgia de Parkinson. O sucesso do procedimento começa com uma indicação precisa, realizada pelo trabalho conjunto entre o Neurologista e o Neurocirurgião, por meio de uma equipe multidisciplinar especializada.
Retinoblastoma
O Hospital Santa Marcelina possui uma das melhores estruturas para o tratamento de retinoblastoma no mundo. O hospital já se tornou uma referência no tratamento e possui os mesmos recursos tecnológicos de centros ultra especializados. Por ano, são atendidos em média 35 pacientes de vários estados brasileiros.
Unidades do Hospital Santa Marcelina
Além da mais conhecida unidade localizada em Itaquera, que possui todos serviços acima citados, o Hospital Santa Marcelina também possui outros hospitais e clínicas de atendimentos espalhados por São Paulo, confira abaixo:
Atenção Primária à Saúde Santa Marcelina

A Atenção Primária à Saúde (APS) Santa Marcelina teve início em 1996, com a implantação das primeiras 27 equipes de Estratégia de Saúde da Família (ESF) no município de São Paulo. Com mais de 20 anos de atividades, a iniciativa se caracteriza pelo cuidado e pela promoção de saúde de quase dois milhões de pessoas que vivem na Zona Leste da Capital.
Endereço: Rua Harry Dannenberg, 276, Itaquera
Telefone: +55 (11) 2344-4600
Hospital Geral do Itaim Paulista
Atualmente, o hospital conta com mais de 301 leitos, sendo 10 da Unidade de Terapia Intensiva Adulto, 16 leitos da neonatal, além de realizar 10 mil atendimentos mensais no Pronto Atendimento, além de diversas especialidades.
Endereço: Av. Marechal Tito, 6035, Itaim Paulista.
Telefone: +55 (11) 2563-6300
Hospital Geral de Itaquaquecetuba
A unidade mantém atendimento de emergência nas especialidades de Clínica Médica, Clínica Cirúrgica, Ginecologia e Obstetrícia, Traumatologia, Ortopedia, Pediatria, Psiquiatria e Neurocirurgia. Além disso, disponibiliza o ambulatório de especialidades de Cirurgia Vascular, Cirurgia Plástica, Cirurgia de Cabeça e Pescoço, Cirurgia Geral, Ginecologia e Mastologia.
Endereço: Rua Rio Negro, 48 – Jd. Nova Itaquaquecetuba
Telefone: +55 (11) 4645-4200
Hospital Cidade Tiradentes
A assistência prestada pela unidade é universal e gratuita à população, com abrangência 100% SUS, seguindo as diretrizes de humanização. Atende todas as especialidades médicas básicas: Clínica Médica, Clínica Pediátrica, Clínica Cirúrgica, Ortopedia e Traumatologia, Ginecologia e Obstetrícia e Psiquiatria.
Endereço: Av. dos Metalúrgicos, 1.797, Cidade Tiradentes – SP
Telefone: +55 (11) 2559-6200
Hospital Neomater
O Hospital Neomater é referência na cidade de São Bernardo do Campo e região do Grande ABC para pronto atendimento cirúrgico em Clínica Médica, Pediatria, Ortopedia e Cirurgia Geral. No local, as urgências e emergências nessas especialidades têm atendimento 24 horas por dia, tanto para o público adulto quanto para o infantil.
Endereço: Av. Winston Churchill, 151- Rudge Ramos – SBC
Telefone: +55 (11) 4336-9100
Hospital Santa Marcelina de Porto Velho (RO)
Em 1975, as Irmãs Marcelinas assumiram a administração de uma colônia de hansenianos – denominada Jayme Aben Athar, situada em plena floresta amazônica, e a transformou no Hospital Santa Marcelina de Porto Velho. Hoje, o hospital conta com 130 leitos e é a principal referência em atendimento de média complexidade para a população da região Norte.
Endereço: BR 364, km17 – Zona Rural – Porto Velho (RO)
Telefone: +55 (69) 3278-2252
Hospital Santa Marcelina de Sapezal
O hospital presta atendimentos 24 horas, com assistência geral, e tem como objetivo a humanização alinhada à qualidade. Conta com 53 leitos de internação e pronto-socorro. Oferece serviços de especialidade em Ginecologia e Obstetrícia, Pediatria, Ortopedia, Clínica Médica, Cirurgia Geral, Anestesiologia, Serviços de Diagnóstico por Imagem, além dos exames laboratoriais.
Endereço: Av. Pirambóia, 960 – Sapezal – MT
Telefone: +55 (65) 3383-1760
Convênios médicos atendidos
Visando atender o maior número de pessoas possível, o Hospital Santa Marcelina está credenciado para atender uma vasta diversidade de convênios médicos. Para conferir a lista completa basta clicar aqui.
Para ter acesso à essas unidades que oferecem tratamento e equipamentos de ponta, adquira agora um plano de saúde que tenha o Hospital Santa Paula em sua rede credenciada. Caso esteja na dúvida sobre qual convênio escolher, utiliza nosso simulador gratuito e veja qual plano combina mais com você e seu bolso.





